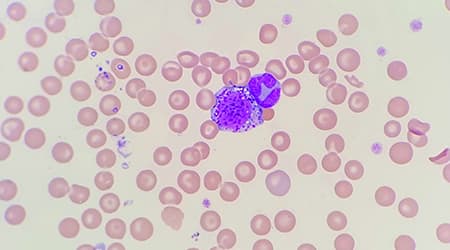

When Fleas & Ticks Necessitate a Trip to the ER
June 7, 2024
When Fleas & Ticks Necessitate a Trip to the ER
What is Pulmonary Hypertension (PAH)?
May 31, 2024
What is Pulmonary Hypertension (PAH)? By: Risa Roland, DVM, DACVIM (Cardiology)
Things to Keep in Mind when Traveling With your Dog
May 17, 2024
Things to Keep in Mind when Traveling With your Dog
Preparing Your Dog for Life with a Baby
May 10, 2024
Preparing Your Dog for Life with a Baby By: Hagar Hauser, DVM, DACVB